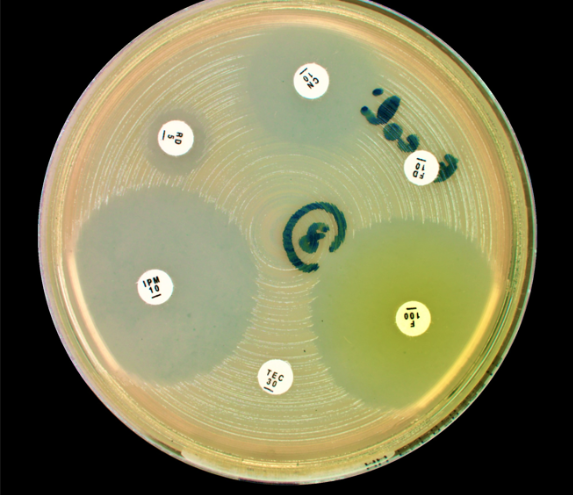

Home / Communicating / Lay Communication / Activities / DIPLAB
DIPLAB
Soirée Antibiorésistance: Exploring Antibiotic Resistance at the Musée de la Main

On 28 November 2024, the Musée de la Main in Lausanne hosted an innovative public
workshop on antimicrobial resistance (AMR), titled Soirée Antibiorésistance. The event was the
result of a collaboration between the SUPSI Institute of Design, the Institute of Microbiology
of the CHUV (IMUL), and the museum itself. Open to the general public, the workshop
combined expert talks, hands-on lab demonstrations, and digital tools to demystify how
bacteria develop resistance and how antibiotics are tested.
The evening began with a welcome by Roxanne Currat, curator at the Musée de la Main, followed by an introduction to microbiology and AMR by Prof. Gilbert Greub (director of IMUL) and Alexandre Delfino (MD-PhD student, IMUL). The practical activities were led by Matteo and Ginevra, PhD students at SUPSI involved in the Interaction Design program
Workshop Part 1 – Seeing Bacteria Firsthand
Under the guidance of Prof. Greub and Alexandre Delfino, participants observed Gram-stained bacteria through microscopes, learning to distinguish bacterial species by their color, morphology, and arrangement. They also explored antibiograms (Kirby-Bauer disc diffusion tests), which revealed how different bacterial species respond to antibiotics. The exercise highlighted the challenges of AMR, such as delayed test results and the urgent need for faster diagnostic methods.

Left picture: Microscopy of a sample containing a cell and multiple bacteria stained using the Gram staining method.
Right picture: Antibiogram of an Escherichia coli using the Kirby-Bauer method—or disc diffusion test.
Workshop Part 2 – The Digital Petri Lab (DiPLab)
The second part introduced DiPLab, a digital tool that simulates antibiotic susceptibility testing. Using handheld consoles, participants carried
out virtual antibiograms, interpreting inhibition zones and selecting effective treatments in simulated patient cases. The digital format allowed
for collaborative learning, with visualization tools showing bacterial growth dynamics in real time. Originally tested during SATW’s TechDay
Initiative in Swiss secondary schools, DiPLab makes it possible to replicate antibiotic testing in classrooms without safety risks or waiting
times.

The image on the left shows two participants interacting with the DiPLab tool to retrieve some information regarding antibiotic resistance. Picture from the session run at Musée de la
Main, on November 28th, 2024.

The screenshot is taken from the video tutorial performed to onboard educators in the use of the Digital Petri Laboratory.
A Stimulating Evening of Science
The event concluded with informal discussions over an aperitif, giving participants the chance to reflect on their experiences and ask further
questions. By combining authentic laboratory observation with interactive digital tools, Soirée Antibiorésistance offered participants a
memorable way to engage with a critical global health issue—highlighting the importance of responsible antibiotic use while sparking
curiosity about the hidden world of microbes.
